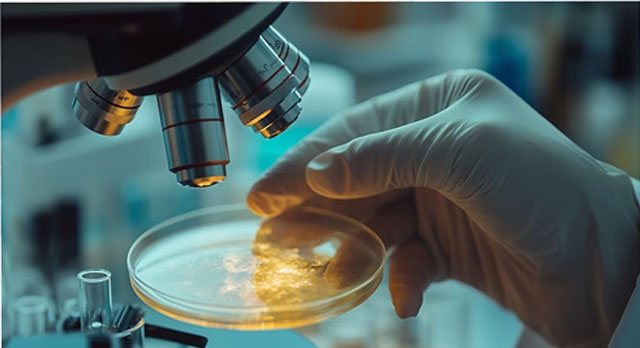

La Administración Nacional de Medicamentos, Alimentos y Tecnología Médica (ANMAT) adoptó una serie de medidas en el contexto de su estrategia de revisión de las actividades de laboratorios con incumplimientos críticos.
Se dispuso la inhibición total de actividades a BIOTENK S.A. y LABORATORIOS SOLKOTAL S.A., al tiempo que se procedió a la baja de habilitación de ocho establecimientos tras detectar inactividad y carencias de conducción técnica, en cumplimiento con la Ley Nº 16.463.
Las resoluciones, parte de un proceso de revisión a fondo que busca optimizar recursos y agilizar la vigilancia, marcan un cambio de rumbo en la política sanitaria: el organismo pretende así eliminar demoras y reafirmar su capacidad regulatoria. Cabe recordar que días atrás se anunció a Luis Fontana como nuevo titular de la entidad.
Las investigaciones más recientes, según comunicó ANMAT, llevaron a la inhabilitación de BIOTENK S.A, un laboratorio orientado a la venta masiva y libre de medicamentos. El Instituto Nacional de Medicamentos (INAME), tras una inspección, expuso la inexistencia formal de un área de farmacovigilancia en la empresa, junto a la falta sistémica de notificaciones de reacciones adversas.
El Instituto Nacional de Medicamentos detectó en uno de los laboratorios la falta de un área de farmacovigilancia, la ausencia de notificaciones sobre reacciones adversas y la inexistencia de procedimientos estandarizados actualizados, factores que motivaron la inhabilitación definitiva
El informe da cuenta de ausencia de revisión de la literatura científica, de informes periódicos de seguridad y de procedimientos estandarizados actualizados. El laboratorio tampoco realizó capacitaciones, ni dispuso de los recursos humanos y materiales mínimos para que la farmacovigilancia funcionase de manera adecuada. Tras constatar estos incumplimientos, ANMAT otorgó a la firma un plazo para entregar un plan de acciones correctivas y preventivas (CAPAs), pero la empresa no cumplió con la presentación en tiempo y forma, lo que motivó la suspensión de sus actividades.
El caso de LABORATORIOS SOLKOTAL S.A. es igualmente representativo. La inspección impulsada por el INAME encontró ausencia de personal calificado, carencia de un sistema robusto de gestión de calidad, importantes deficiencias en instalaciones y equipos sin mantenimiento ni calibración adecuada. Se detectó también una incorrecta segregación y rotulación de materiales y productos, incumplimientos en los sectores de producción y control de calidad, y actividades tercerizadas desarrolladas sin la autorización ni documentación sanitaria exigida.
Un hallazgo especialmente relevante fue que Solkotal producía inyectables para Laboratorio P.L. Rivero y CIA S.A., establecimiento que había sido previamente inhibido por disposición de la propia ANMAT. Por este motivo, la autoridad ordenó recuperar del mercado todos los lotes de esos productos fabricados por Solkotal, medida que busca evitar riesgos adicionales para la salud pública.
En el último año, Laboratorios Solkotal S.A. había presentado antecedentes de irregularidades. En 2022, tras una suspensión inicial, el laboratorio recibió la luz verde para volver a producir soluciones parenterales de gran volumen, bajo seguimiento estricto de ANMAT y un compromiso formal de subsanar las deficiencias señaladas, en acuerdo con el Ministerio de Trabajo y el Ministerio de Salud. La reincidencia y la falta de cumplimiento motivaron la inhibición definitiva.
De manera paralela, el organismo retiró la habilitación de ocho laboratorios y droguerías por no cumplir con las exigencias de actividad productiva y de designación de director técnico. Este grupo lo componen: Droguería Eurofarma S.A. (Disposición Nº 8/2026), Jacobo David Sapoznikow (Disposición Nº 11/2026), PAR SOL Laboratorios S.A. (Disposición Nº 5/2026), Spedrog Caillon S.A.I.C. (Disposición Nº 10/2026), Laboratorios Apolo S.A. (Disposición Nº 4/2026), Lab. Factory Solution S.A. (Disposición Nº 6/2026), Laboratorio Redia S.A. (Disposición Nº 3/2026) y Lemax Laboratorios S.R.L. (Disposición Nº 7/2026).
El “Registro de Inscripción de Establecimientos” detectó su inactividad productiva y la ausencia de responsable técnico, infracción que la Ley Nº 16.463 considera excluyente para mantener la habilitación. Esta situación llevó a ANMAT a cancelar sus permisos de operación con efecto inmediato, reforzando la regla de que no puede haber laboratorios habilitados sin actividad ni conducción profesional validada por la autoridad sanitaria.
El nuevo titular de la ANMAT
La designación de Luis Fontana como titular de la ANMAT responde al objetivo de asegurar la continuidad y robustecer el perfil técnico-científico del organismo
El impulso de estos controles tiene su origen directo en la reconversión institucional liderada por Luis Fontana, quien asumió recientemente como titular de ANMAT tras la salida de Agustina Bisio. El Gobierno nacional buscó asegurar la continuidad y robustecer el perfil técnico-científico del organismo designando a Fontana, médico cirujano egresado de la Universidad de Buenos Aires, especializado en administración de empresas de salud, dirección estratégica, sistemas de información y negociación.
Con más de 30 años de trayectoria, vivió etapas clave en OSDE, donde se desempeñó como director general, director médico de servicios asistenciales, gerente médico, jefe de residentes y cirujano de planta en el Instituto Ángel Roffo.
En todos sus cargos, Fontana impulsó esquemas de ordenamiento y modernización con una visión puesta en la eficiencia, la digitalización y la toma de decisiones basada en datos.
Esta línea de trabajo constituye ahora el eje rector de la nueva gestión, que apunta a transformar ANMAT en una entidad ágil, transparente y estrictamente regulatoria. Entre los objetivos explícitos de Fontana se cuenta el “ordenamiento administrativo”, la erradicación de estructuras ineficaces, la optimización de recursos y la reducción de tiempos burocráticos.
Fuente Infobae